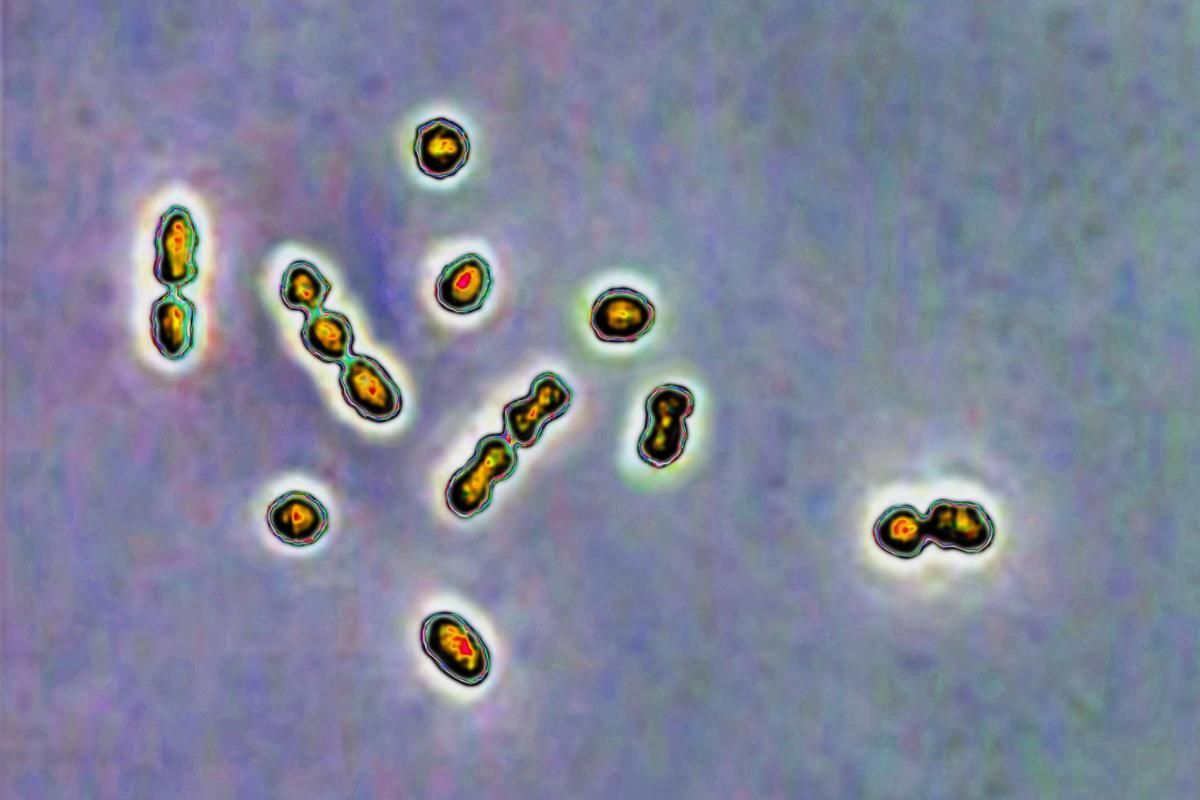

Dos niños muertos y 14 hospitalizados por estreptococo A en Madrid en las últimas semanas
Se trata de dos pequeñas que fallecieron tras presentar un cuadro clínico de evolución muy severa a su llegada a los servicios de urgencias hospitalarios.
Dos menores han muerto y otros 14 han precisado ingreso hospitalario en la Comunidad de Madrid en las últimas semanas por enfermedad invasiva por estreptococo A (meningitis, shock séptico o neumonías).
En concreto, desde el pasado día 19 de octubre hasta la fecha se han detectado 16 casos de estreptoco A en la región en menores con edades comprendidas entre 1 y 12 años, según han indicado a Europa Press fuentes de la Consejería de Sanidad.
De ellos, dos niñas han fallecido, una el 25 de octubre y otra el 2 de diciembre, al presentar un cuadro clínico de evolución muy severa a su llegada a los servicios de urgencias hospitalarios.
Los 14 casos restantes
Los otros 14 casos diagnosticados están ingresados con el correspondiente tratamiento antibiótico y evolucionan de forma favorable, han indicado desde el departamento que dirige Enrique Ruiz Escudero.
La Agencia de Seguridad Sanitaria de Reino Unido ha activado una alerta sanitaria ante el incremento de casos por estreptococo A durante las últimas semanas, con varios niños fallecidos.
Tras esta alerta, la Consejería de Sanidad está estudiando desde el pasado 5 de diciembre si en estos momentos la frecuencia de enfermedad invasiva por estreptococo A es superior a lo detectado en la etapa previa a la pandemia por Covid-19.
Estas infecciones respiratorias no son objeto de declaración obligatoria, por lo que la Dirección General de Salud Pública está estudiando si existe o no una mayor incidencia.
Enfermedad invasiva, una de las formas más graves
La enfermedad invasiva por estreptococo A es una de las formas más graves producidas por esta bacteria, patógeno que con frecuencia produce una gran variedad de procesos infecciosos, desde la faringitis, la amigdalitis, la escarlatina, e incluso infecciones invasivas y graves como la fascitis necrotizante o el shock séptico.
Esta patología se disemina por gotitas respiratorias, el contacto con las mucosas oral o nasal con secreciones respiratorias infecciosas o con exudados de lesiones cutáneas.
La infección es transmisible hasta 24 horas después de haber completado el tratamiento antibiótico. La Consejería de Sanidad ha recomendado seguir las indicaciones de tratamiento del médico y ante la presencia de fiebre alta y empeoramiento de síntomas respiratorios y decaimiento, acudir a una urgencia hospitalaria.
